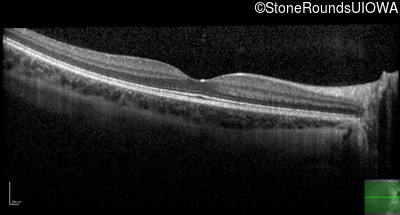
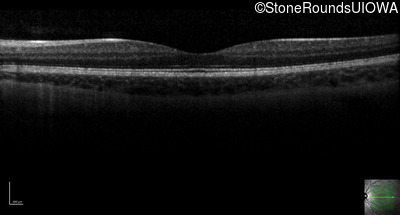
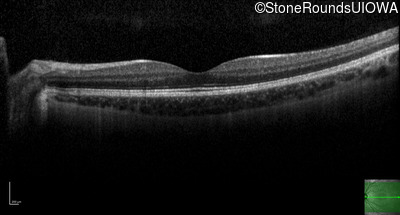
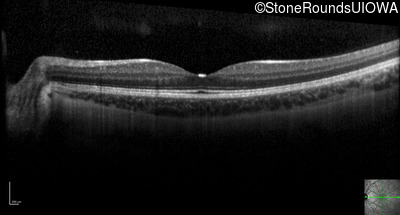

Case
SR1751
Student Mode
North Carolina Macular Dystrophy (IIG)
Female
Female
Hidden
SR1751
Student Mode
North Carolina Macular Dystrophy (IIG)
Female
Female
Visit at age: 12 years
Fundus Photography - Right - 20/16 -1
Fundus Photography - Left - 20/16 -1
Fundus Montage - Right - 20/16 -1
Fundus Montage - Left - 20/16 -1
Goldmann Visual Field - Right - 20/16 -1
Goldmann Visual Field - Left - 20/16 -1
Optical Coherence Tomography - Right - 20/16 -1
Optical Coherence Tomography - Left - 20/16 -1
Infrared Fundus Photograph - Right - 20/16 -1
Infrared Fundus Photograph - Left - 20/16 -1
Visit at age: 15 years
Goldmann Visual Field - Right - 20/16 -1
Goldmann Visual Field - Left - 20/20 -1
Diagnosis & molecular findings
| Disease | Gene | Allele 1 variant(s) | Allele 2 variant(s) | Inheritance mode |
|---|---|---|---|---|
| North Carolina Macular Dystrophy | IRX1 | chr5:4396927-4440442dup | AD |
Disease:
Gene:
Allele 1:
chr5:4396927-4440442dup
Allele 2:
Inheritance:
AD